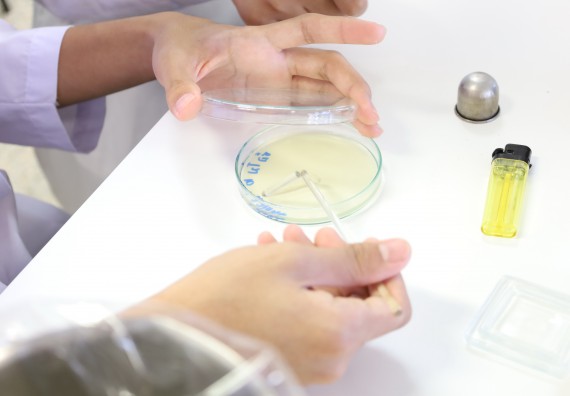
ภาพกิจกรรม  คณะวิทยาศาสตร์และเทคโนโลยี ร่วมกับโรงเรียนพิจิตรพิทยาคม จัดโครงการพัฒนาผู้เรียนมีผลสัมฤทธิ์ทางวิชาการ กิจกรรมพัฒนาศักยภาพนักเรียนห้องเรียนพิเศษวิทยาศาสตร์ฯ SMAT

คณะวิทยาศาสตร์และเทคโนโลยี ร่วมกับโรงเรียนพิจิตรพิทยาคม จัดโครงการพัฒนาผู้เรียนมีผลสัมฤทธิ์ทางวิชาการ กิจกรรมพัฒนาศักยภาพนักเรียนห้องเรียนพิเศษวิทยาศาสตร์ฯ SMAT ม.ปลาย ปีการศึกษา 2566 (กิจกรรมค่ายเทคนิคปลอดเชื้อ) ระดับชั้นมัธยมศึกษาปีที่ 4/10 จำนวน 30 คน ในวันพุธที่ 22 พฤศจิกายน 2566 เวลา 08.30-15.00 น. "ณ อาคารเรียนและปฏิบัติการทางวิทยาศาสตร์ คณะวิทยาศาสตร์และเทคโนโลยี (อาคาร 48) มหาวิทยาลัยราชภัฏกำแพงเพชร" โดยมีอาจารย์และนักศึกษาสาขาวิชาชีววิทยา เป็นวิทยากร

งานพัฒนาสารสนเทศและงานประชาสัมพันธ์